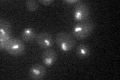
YDR110W
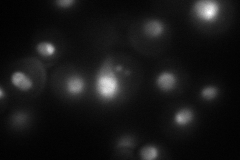
YDR110W
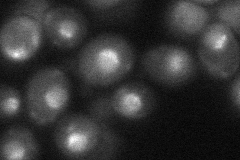
YDR110W

View description
Nucleolar protein that binds the rDNA replication fork barrier (RFB) site; required for replication fork blocking, recombinational hotspot activity, condensin recruitment to RFB and rDNA repeat segregation; related to retroviral integrases
Localization:
Intensity:
Fold change:
Significance:
-
C’ GFP library in SD
nucleolus25.29 -
N' NOP1pr-GFP in SD
nucleolus71.7476 -
N' TEF2pr-mCherry in SD

nucleus58.5543 -
N' NATIVEpr-GFP in SD

punctate,nucleus21.8824 -
N' TEF2pr-VC and Cyto-VN in SD
nucleus,nucleolus35.7223 -
C’ GFP library in SD+DTT

nucleolus27.141.07No -
C’ GFP library in SD+H2O2

nucleolus24.970.98No -
C’ GFP library in Starvation Media

nucleolus23.470.92No -
C’ GFP library on the background of Pup2-DaMP

nucleolus -
C’ GFP library on the background of CCT mutant

nucleolus31.0121.22606No
